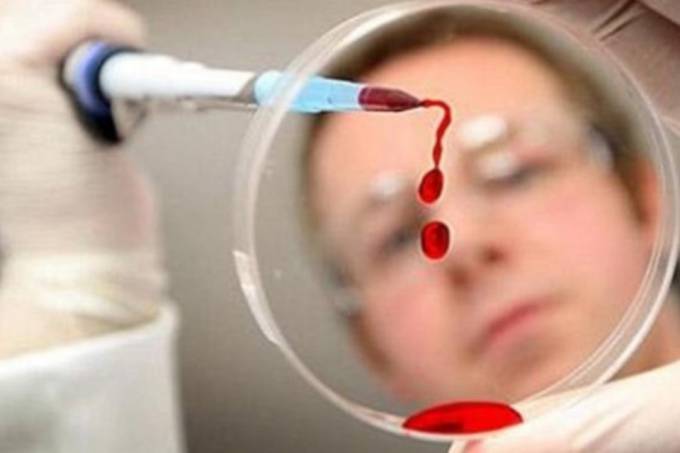
Atualmente, é preciso esperar cerca de 30 dias - período conhecido como "janela imunológica" - para que a presença do vírus seja detectável

Atualmente, é preciso esperar cerca de 30 dias – período conhecido como “janela imunológica” – para que a presença do vírus seja detectável em um exame.
Uma equipe do CSIC “desenvolveu um biossensor que pode chegar a detectar o HIV tipo 1 durante a primeira semana depois da infecção”, anunciou em um comunicado o CSIC, a principal instituição pública dedicada à pesquisa na Espanha.
Os experimentos realizados com soro sanguíneo (líquido do sangue livre dos fatores de coagulação) permitiram detectar uma proteína presente no Vírus da Imunodeficiência Humana do tipo 1 (HIV-1), o antígeno p24, através de um dispositivo particular.
Este dispositivo permite que o p24 fique preso “entre as nanopartículas de ouro e as estruturas micromecânicas de silício”, disse à AFP o pesquisador Javier Tamayo, do Instituto de Microeletrônica de Madri, indicando que os sinais mecânicos e ópticos que são produzidos permitem detectar o antígeno.
A nova tecnologia é capaz de detectar o antígeno em “concentrações 100.000 vezes inferiores” às dos sistemas atuais, afirmou Priscila Kosaka, também do Instituto de Microeletrônica de Madri, no comunicado.
“Isto reduz a fase indetectável depois da infecção a apenas uma semana”, acrescentou.
Segundo a instituição, a detecção precoce é um fator-chave para melhorar a eficácia dos antirretrovirais e para prevenir a propagação da doença.
Com os testes atuais de quarta geração, a detecção do antígeno p24 pode ser feita apenas após três ou quatro semanas a partir da infecção, segundo o CSIC.
O novo dispositivo permitirá obter os resultados clínicos em menos de cinco horas, no mesmo dia do exame, afirmou Tamayo.
O biossensor “usa estruturas que são fabricadas com tecnologias bem estabelecidas em microeletrônica, o que permite sua produção em grande escala e a baixo custo”, garantiu.
Dois milhões e meio de pessoas são infectadas por ano no mundo pelo HIV, responsável pela Aids. O HIV-1 é o tipo mais comum e agressivo do vírus.
Em 2015, 36,7 milhões de pessoas viviam com HIV no mundo.
Fonte:AFP
Reditado para:Noticias do Stop 2017
Fotografias:Getty Images/Reuters/EFE/AFP